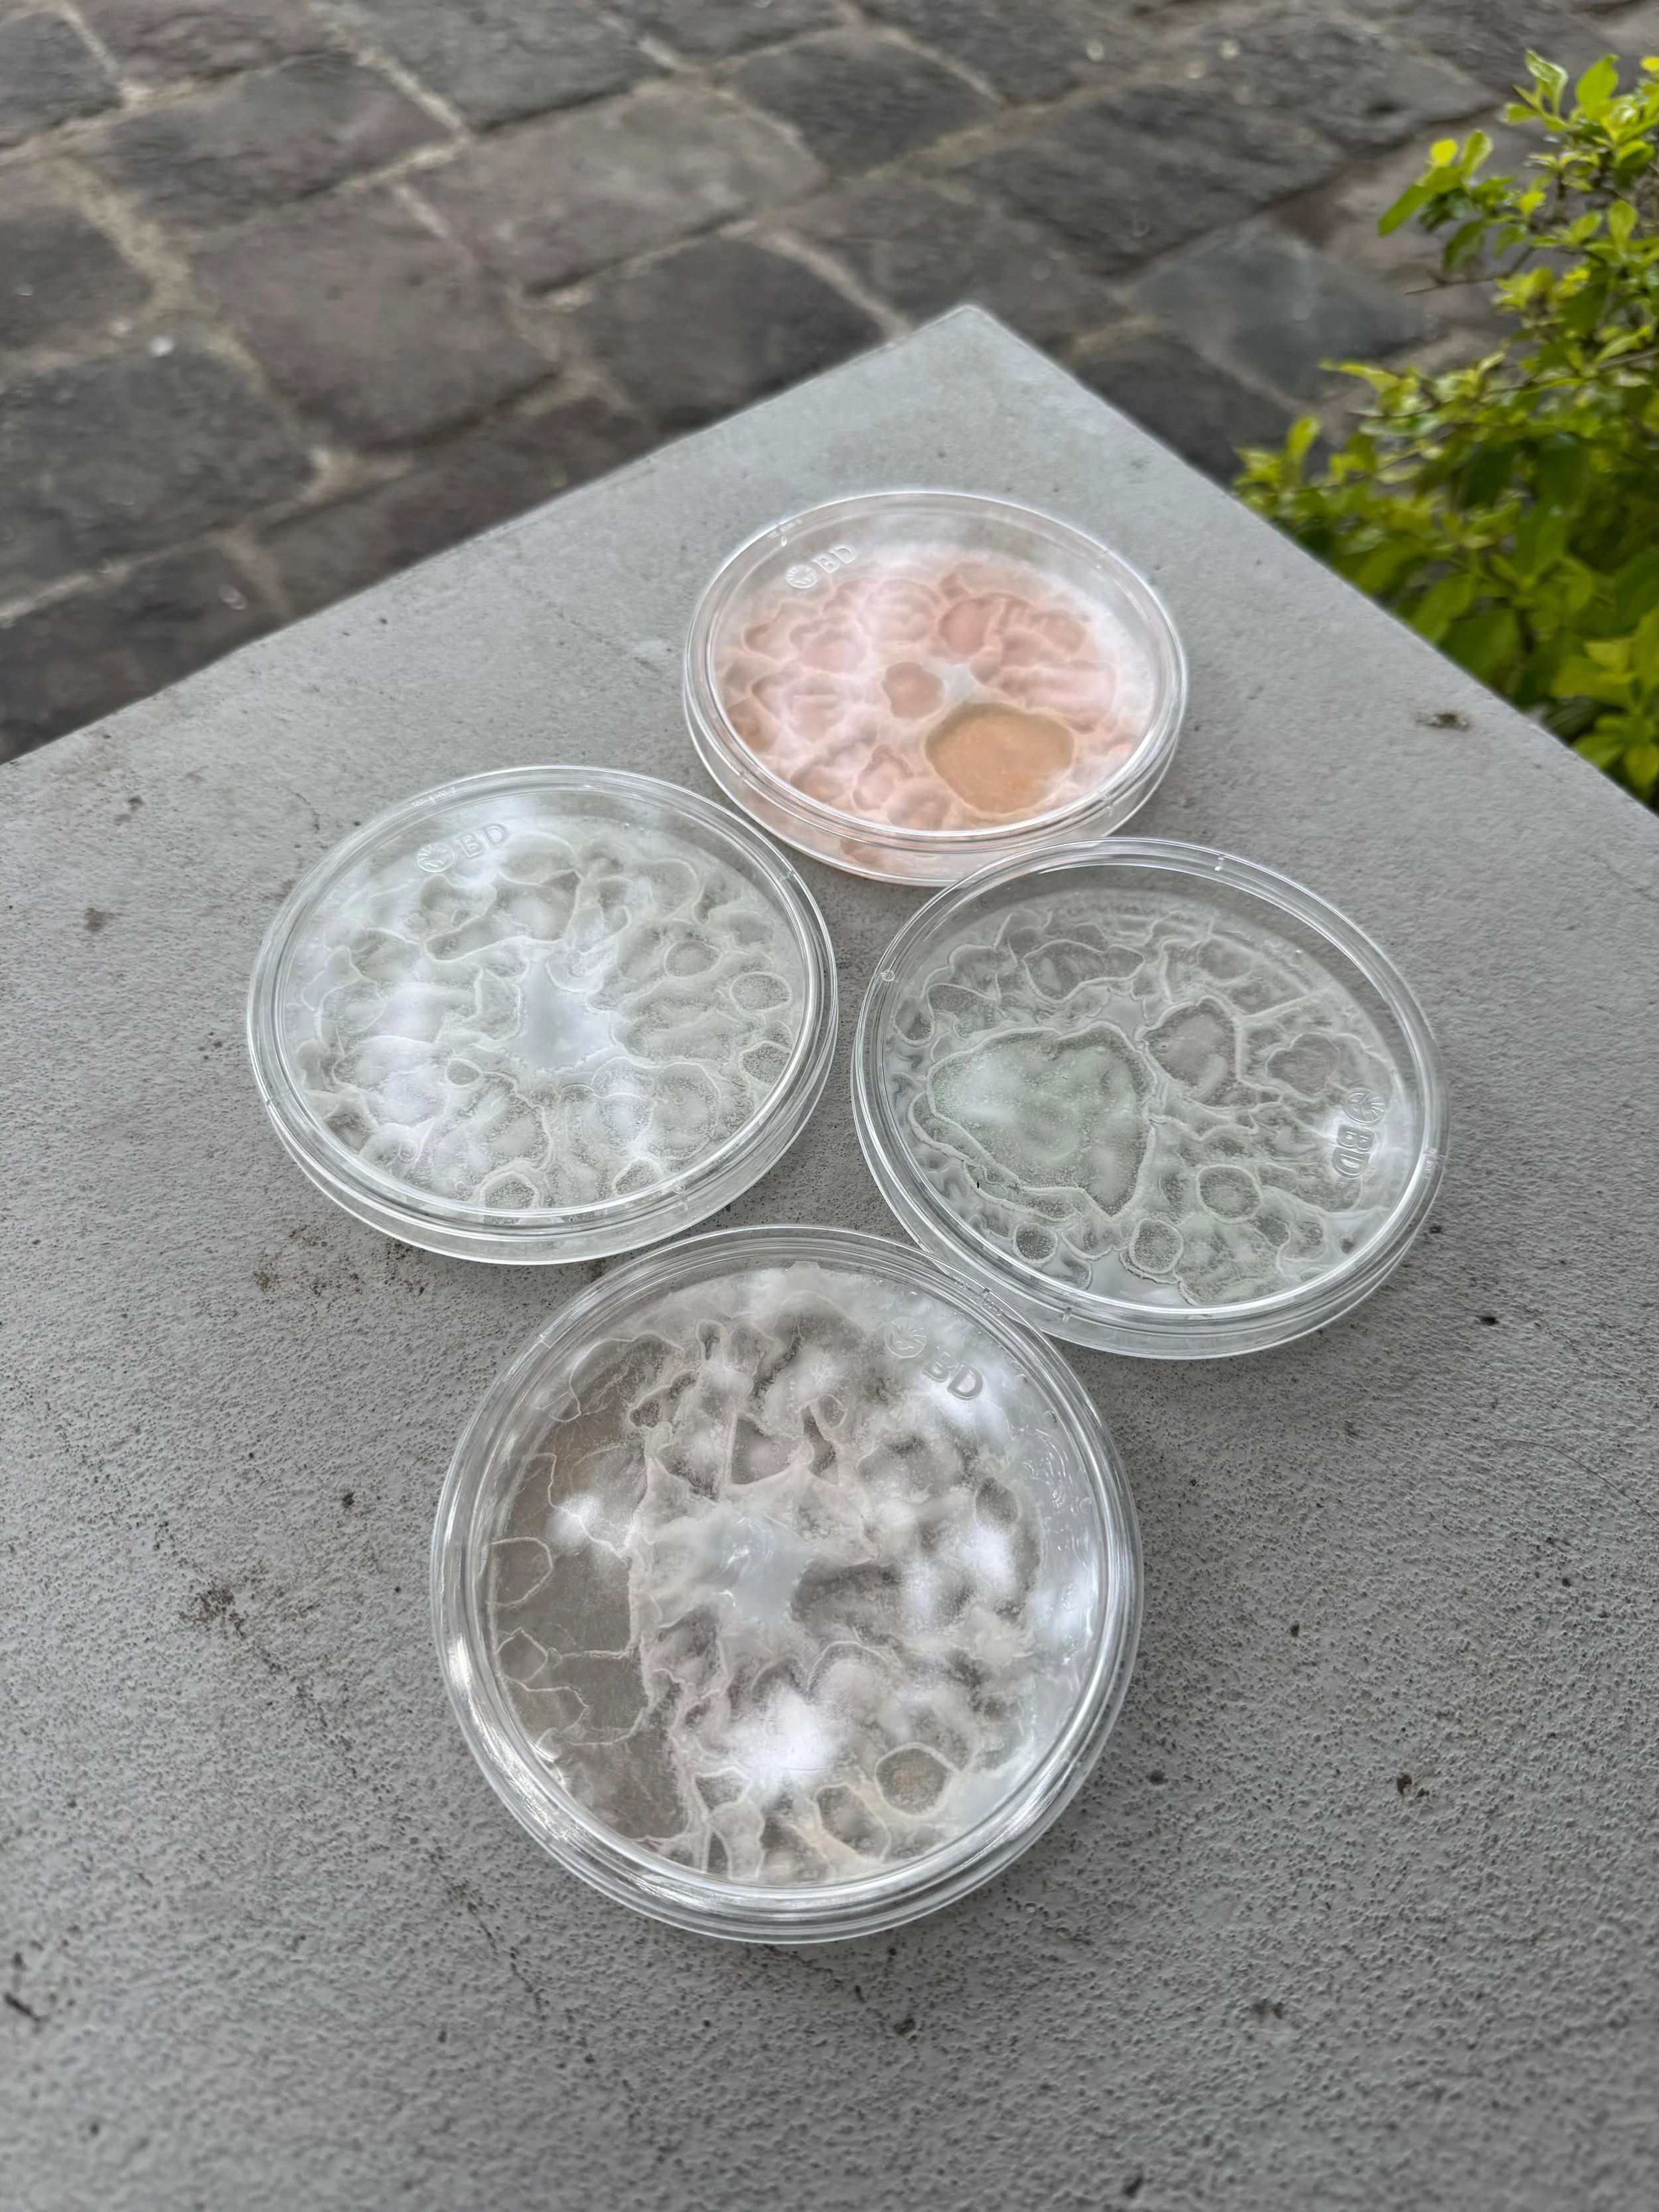

Universidad del Istmo (UNIS)
PROJECTS 2025
UNVEILED
finalist project
Evelyn Sophia Alexandra Herrera Sosa, María Isabel Sosa Arias, Randy Rodrigo Rivera Mayén, Herman Andrés Eccheverría Rojas, José Pablo Valladares Martínez, Carlos Guillermo Álvarez Barquero
UNVEILED raises awareness about fast fashion’s environmental impact through an interactive art and biotechnology exhibition. Using bioluminescent bacteria and reactive chemicals, the exhibit simulates pollution effects on ecosystems. Visitors scan their garments, fibers, and components, triggering a chemical reaction in a Petri dish that visually demonstrates the environmental consequences of their clothing choices in real-time. This immersive experience helps individuals recognize their role in fast-fashion pollution and inspires reflection on sustainable alternatives. By connecting personal habits with ecological harm, UNVEILED encourages responsibility and promotes a shift toward more environmentally conscious fashion decisions.
Instructors 2025
Ana María Cruz de García is an Architect with a Master's degree in University Teaching. She has been the Dean of the Faculty of Architecture and Design of the Universidad del Istmo since 1998, in addition to supporting the teaching of future architects as a professor of courses such as Architectural Design, History of Guatemalan Art, among others. She is the Director of the Master's Degree in Construction and Real Estate Business Management from the Polytechnic University of Madrid and Universidad del Istmo. She has extensive experience in Architectural Design and Development projects at an industrial and housing level under the signature of INARCO, her personal company. She was awarded "Professor of the year 2019" by the College of Professionals and "Architect of the year 2010" by the College of Architects.
Roberto Enrique Sosa Trejo is an Architect with a Master's degree in Planning and Urban Management. It also has a specialization in office design and furniture design. It has combined his professional career with University teaching, being a University professor from 2002 to the present day. He has participated as a consultant and researcher in high impact projects and is interested in the development of new materials and technologies in the field of architecture, furniture and urban equipment. Since 2017 He is the Director of Studies in the Faculty of Architecture and Design of Universidad del Istmo, Also since that year he has been an instructor for the UNIS team for the Biodesign Challenge.
María Antonieta Mendoza Peñalonzo is a professor of investigation at Universidad del Istmo in Guatemala City. She has a PHD degree in architecture from the School of Architecture of the University of Navarra (ETSAUN), Spain. She serves as Director of Investigation of the Architecture and Design Faculty Departament since 2019 at Universidad del Istmo. She specializes in art and architecture of Guatemala in the 1960’s as a synthesis of Guatemalan history and identity.
María Alejandra Sierra is a Biologist Chemist, with a postgraduate degree in Molecular Biology and Genetics and a Master's Degree in Biotechnology; Biotechnology Coordinator of the Institute of Biological, Biomedical and Biophysical Chemical Research of the Mariano Gálvez University, University Professor and President of the Intersectoral Technical Commission of Biotechnology of Guatemala. Chosen one of the 100 global leaders of Biotechnology by the Global Biotech Revolution, Cambridge UK, and one of the 100 leaders of Biotechnology in Latin America by Allbiotech. Objective: Development of strategic alliances for the implementation of biotechnological projects and their different areas including biodesign, promoting the bioeconomy, and the democratization of science.
Juan Pablo Arocha is a Business Development Manager at a Life and Analytical Sciences Company based in Central America. Juan Pablo has more than 15 years of experience in Genomics, Molecular Diagnostics, Applied Biotechnology and Research and Development. Co-founder of the first community laboratory in Central America. His interest is to build biotechnology-based businesses in the region by provinding access to seed capital, angel investments, a network of mentors and access to infrastructure. Background in International Business and Economics.
Estuardo Antonio Sandoval Acevedo is an experienced professional in the field of automation, software management and digital transformation. He holds various leadership positions, such as Automation Project Manager and Director of the Faculty of Computer Science at the Universidad del Istmo. With a solid background in mechatronics, industrial electronics and computer science, Estuardo specializes in ERP systems, agile project management and advanced technology solutions. He recently completed his Executive MBA with a specialization in Data Analytics at Unis Business School and is currently pursuing a PhD in Computer Science. In addition, he has various certifications, such as Scrum Master, Product Owner, and certified LabVIEW developer, among others. Estuardo is passionate about continuous improvement and the implementation of innovative solutions that optimize processes and increase organizational productivity.